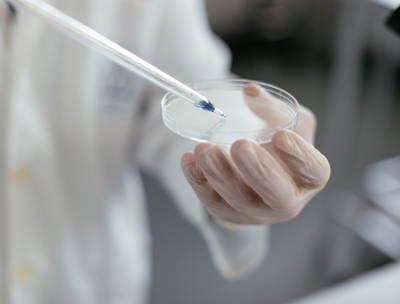

FOR ALL YOUR HEALTH & FITNESS NEEDS
Greetings and welcome to MTC Pharma Labs, your trusted and dependable destination for all your health and fitness requirements.
At MTC Pharma Labs, we are dedicated to ensuring that you receive only the highest quality products sourced from reputable laboratories, guaranteeing that every item you receive is 100% genuine and of the utmost quality.

About Us
Who Are MTC Pharma
MTC Pharma is a biopharmaceutical company with expertise in developing innovative products in multiple therapeutic areas.
We create an innovative healthcare platform by bridging unique talents and assets across different cultures and backgrounds.
Each day, we bring to work our passion to develop sustainable drug treatments and contribute to improving human health and quality of life around the globe.
providing unprecedented innovative drugs
for the Performance enhancing athletic Markets

The First step till Victory
we provide a Wide range of Steroids Hormonals. We are not just manufacturing Them , but we Do improving them !

Purity & BioAvailability
We ensure our Users a absorption and BioAvailability of any of our substances to 99.8%. This is the Reflect of High Purity Raw Materials used during the manufacturing Process.

Endurance , Strength .PERFORMANCE !!
We helped so many atheletes & Patients since many Years . We strive to offer the finest potent stuff in the market .
ANTI-COUNTERFEITING SYSTEM
DON’T ACCEPT PRODUCTS WITH PROTECTION LINE THAT HAVE BEEN SCRATCHED OFF.
• ONLY ACCEPT PRODUCTS WITH INTACT AUTHENTICATION LINE.
• ONLY BUY FROM AUTHORIZED SELLERS.
Why Choose Us
9 reasons to choose
MTC Pharma Labs products.

- All of our raw materials undergo the HPLC method (with assay results consistently at 99% or higher, ensuring freedom from impurities such as heavy metals and carcinogens)
- We maintain a higher-than-usual standard for sterile contamination, employing unique culture media. If even the slightest contamination is detected, the entire batch is discarded
- We guarantee the full dosage strength in our finished products, which can be verified by any analysis laboratory
- Our packaging offers several advantages: it is user-friendly, undergoes a non-contaminated packaging process, and is available in single and multiple-dose packs, as well as disposable and easy-to-carry options
- We provide excellent quality at a reasonable price
- We ensure complete security through authenticity codes on all MTC Pharma Labs products, which can be verified on our website. The absence of an authenticity code sticker on our products indicates that the product is counterfeit
- All pharmaceutical processes and email product information responsiveness are overseen by a team of pharmacists
- You can easily visit us by scanning the QR code printed on our products, which allows you to check the authenticity of your product and access the product leaflet for more information
- We offer a full range of anabolic/androgenic hormone products, with a total of 45 varieties of injectable and oral products
